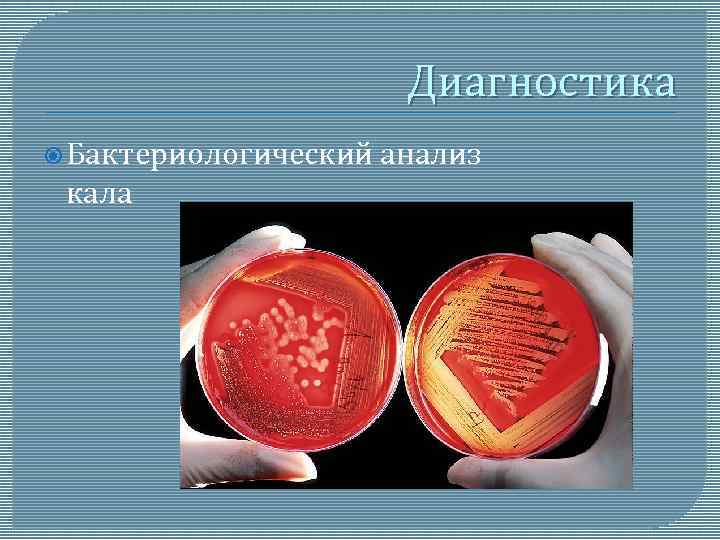

Сальмонеллез Самонина Л. А. Группа Ф-131
Сальмонеллез Самонина Л. А. Группа Ф-131
 Сальмонеллез – это… Острое инфекционное антропозоонозное заболевание, вызываемое сальмонеллами и характеризующееся, в общем случае, развитием интоксикации и поражением желудочно-кишечного тракта.
Сальмонеллез – это… Острое инфекционное антропозоонозное заболевание, вызываемое сальмонеллами и характеризующееся, в общем случае, развитием интоксикации и поражением желудочно-кишечного тракта.
 Сальмонелла Род неспороносных бактерий, имеющих форму палочек (длина 1— 7 мкм, ширина около 0, 3— 0, 7 мкм). Сальмонеллы являются грамотрицательными подвижными анаэробными палочками, патогенны для людей и животных при пероральном введении.
Сальмонелла Род неспороносных бактерий, имеющих форму палочек (длина 1— 7 мкм, ширина около 0, 3— 0, 7 мкм). Сальмонеллы являются грамотрицательными подвижными анаэробными палочками, патогенны для людей и животных при пероральном введении.
 Основной источник инфекции пищевые реже в продукты больное животное отдельных случаях источником заражения может быть человек (больной или бактерионоситель)
Основной источник инфекции пищевые реже в продукты больное животное отдельных случаях источником заражения может быть человек (больной или бактерионоситель)
 Механизмы передачи Фекально-оральный Контактно-бытовой Пищевой Водный
Механизмы передачи Фекально-оральный Контактно-бытовой Пищевой Водный
 Основной источник инфекции Заражение происходит через инфицированные пищевые продукты, как правило, животного происхождения: Плохо термически обработанная курица
Основной источник инфекции Заражение происходит через инфицированные пищевые продукты, как правило, животного происхождения: Плохо термически обработанная курица
 Основной источник инфекции Парное Сырые молоко яйца (утиные, гусиные и куриные)
Основной источник инфекции Парное Сырые молоко яйца (утиные, гусиные и куриные)
 Клинические проявления Заболевание обычно начинается остро, обильной рвотой и поносом (стул водянистый, часто со слизью, зловонный). Наблюдаются боли, урчание и вздутие живота, слабость, головная боль, головокружение, озноб, повышение температуры до 38— 41°С, боли в мышцах и суставах, судороги мышц конечностей.
Клинические проявления Заболевание обычно начинается остро, обильной рвотой и поносом (стул водянистый, часто со слизью, зловонный). Наблюдаются боли, урчание и вздутие живота, слабость, головная боль, головокружение, озноб, повышение температуры до 38— 41°С, боли в мышцах и суставах, судороги мышц конечностей.
 Осложнения Перитонит Токсическое расширение кишки Полиартрит Инфекционнотоксический шок
Осложнения Перитонит Токсическое расширение кишки Полиартрит Инфекционнотоксический шок
Диагностика Бактериологический кала анализ
Диагностика Бактериологический кала анализ
 Лечение Регидрон Левомецетин
Лечение Регидрон Левомецетин
 Лечение Мезим Линекс Папаверин
Лечение Мезим Линекс Папаверин
 Профилактика Соблюдение санитарно-гигиенических норм и правил Термическая Чистая обработка пищи и воды посуда Ветеринарно-санитарный надзор за убоем скота и обработкой туш
Профилактика Соблюдение санитарно-гигиенических норм и правил Термическая Чистая обработка пищи и воды посуда Ветеринарно-санитарный надзор за убоем скота и обработкой туш
 Мероприятия в очаге Госпитализация больных (в отдельных случаях и носителей) проводится по клиническим и эпидемиологическим показаниям. Тщательная уборка помещения, где присутствовал больной, с уничтожением остатков инфицированной пищи. Мероприятия в отношении контактировавших включают наблюдения за ними в течении недели с посещение очага на 2, 5, 7 -й день после появления больного.
Мероприятия в очаге Госпитализация больных (в отдельных случаях и носителей) проводится по клиническим и эпидемиологическим показаниям. Тщательная уборка помещения, где присутствовал больной, с уничтожением остатков инфицированной пищи. Мероприятия в отношении контактировавших включают наблюдения за ними в течении недели с посещение очага на 2, 5, 7 -й день после появления больного.
 Спасибо за внимание!
Спасибо за внимание!